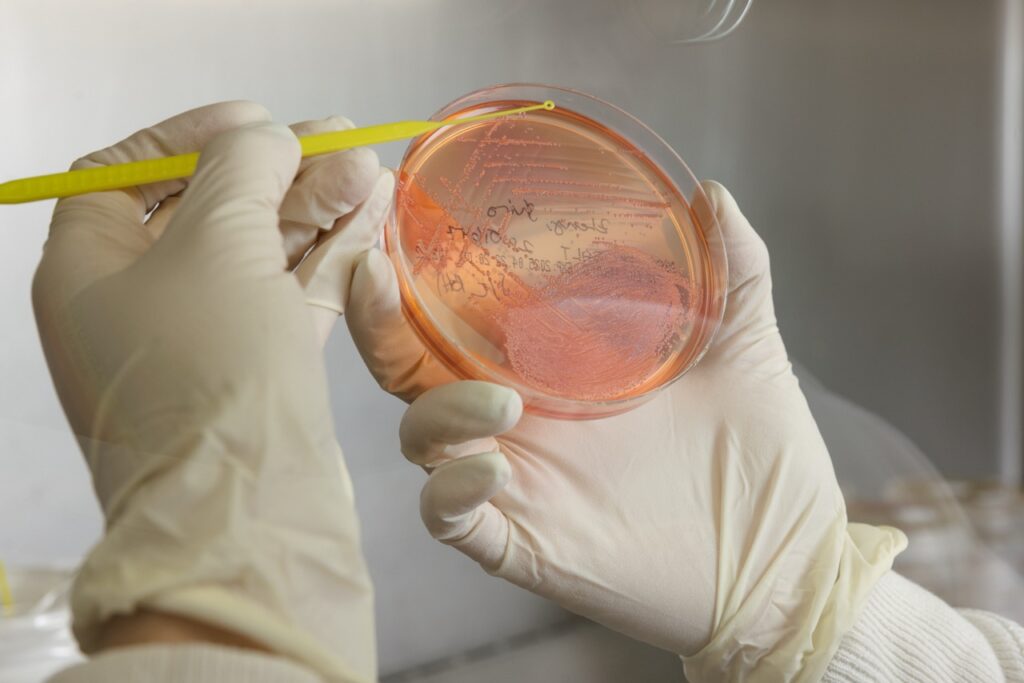

Education
Sending samples to The University of Sydney contributes directly to the teaching and learning of our veterinary pathology residents and students. VPDS also supports the Doctor of Veterinary Medicine (DVM) program through practical classes and hands-on training, helping prepare future veterinarians with essential laboratory skills.
Research
Our team actively contributes to research and innovation, with over 140 articles published in high-quality, peer-reviewed journals. We share this expertise to assist your team in publishing interesting cases and meeting requirements for specialist qualification.
Why Partner With Us?
Through collaboration, technical excellence, and a commitment to advancing veterinary science, VPDS serves as a reliable partner for clinicians, researchers, and educators. When you work with us, you’re supporting diagnostics that make a difference—and contributing to the future of veterinary medicine.
Ready to work with VPDS?
VPDS is NATA‑accredited (ISO/IEC 17025) for selected diagnostic services, reflecting our commitment to quality, competence, and reliable results. For details of the scope, visit NATA VPDS Sydney / NATA VPDS Camden.
Latest News
-

Canine blood bank
Give the gift of life Dogs and their owners can give the gift of life to other dogs thanks to our blood bank at the University Veterinary Teaching Hospital Sydney.
-

Ancient spaghetti in dog hearts reveals origins of heartworm
Global DNA study rewrites the evolutionary history of canine disease.